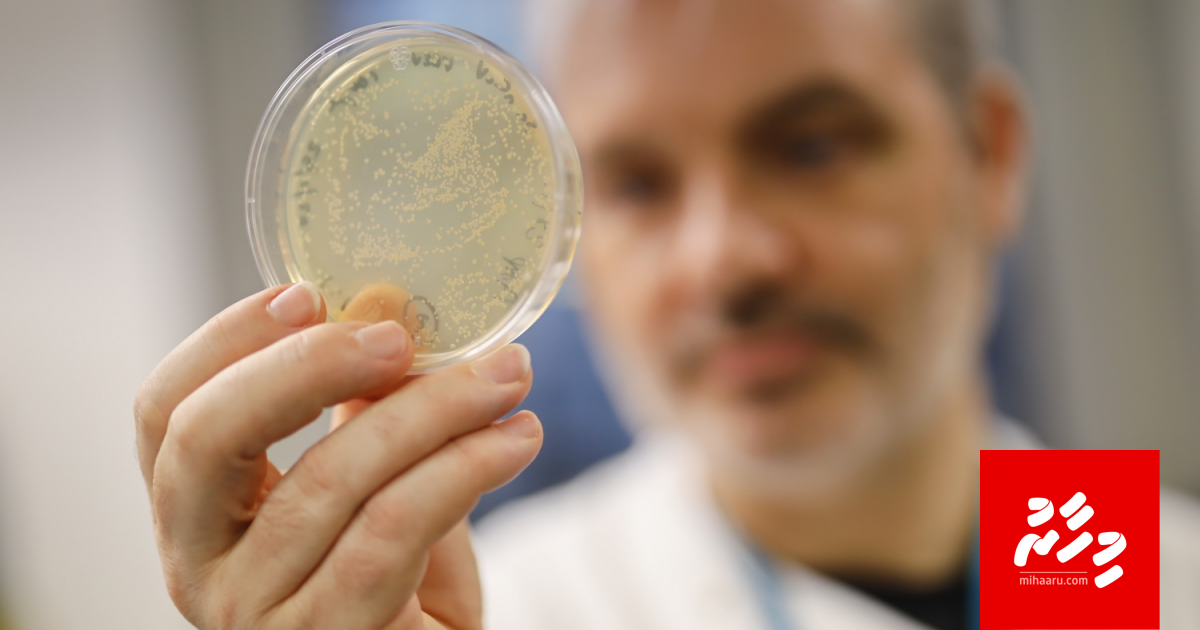
Novel Coronavirus ah enme fahun nameh dheefi

އާ އަހަރަކާ މުޅި ދުނިޔެ ކުރިމަތިލައި، 2020 ގައި ކުރާނެ ވަރަށް ގިނަ ކަންތައްތަކެއް ރާވަމުން ދަނިކޮށް މުޅި ދުނިޔެ މިހާރު މިއޮތީ ކޮވިޑް-19 ގެ ބަލިމަޑުކަމާ އެކު ހުއްޓުމަކަށް އައިސްފަ އެވެ. އިންސާނުންގެ ދިރިއުޅުމަށް ކުރިން ނާންނަ ވަރުގެ ބޮޑު ބަދަލެއް، ބޮޑު ތާށިކަމަކާ އެކު ބޮޑު ބަންދަކުން މިއޮތީ ބަންދުވެފަ އެވެ.
މި ހާލަތުން އަރައިގަނެވޭނެ އިރެއް ނޭނގި ބަންދުވެފައި ތިބެގެން އަހަރެމެންގެ ބަސްކޮށާރަށް ބަސްތަކެއް އާންމު ވެސް ވެއްޖެ އެވެ.
މި ބައްޔާ އެކު ބޭނުންކުރާ ބޭރު ބަސްތައް އަހަރެމެންގެ ތެރޭގައި ގިނަ އެވެ. އެކަމަކު އެހެން ބަސްތަކެއް ވެސް މިހާރު އާންމުކޮށް ބޭނުންކުރެ އެވެ.
ފުރަތަމަ ވެސް ނޮވެލް ކޮރޯނާވައިރަހެވެ. މި ވައިރަހުން ޖެހޭ ބައްޔަށް ވަކި ހާއްސަ ނަމެއް ނެތި އެކި މީހުން އެކި ގޮތަށް ކިޔަމުން ގޮސް ބަލީގެ ނަމަކަށް ކޮވިޑް-19 ހަމަޖެއްސިކަން ދުނިޔޭގެ ސިއްހަތު ޖަމިއްތާ ޑަބްލިއުއެޗްއޯ އިން އިއުލާންކުރީ ފެބްރުއަރީ މަހުގެ ކުރީކޮޅު އެވެ.
ކޮރޯނާވައިރަހުގެ އެކި ވައްތަރުތައް ހުރެ އެވެ. އާ ވައިރަހަށް ނަންދީފައި ވަނީ "ކޮރޯނާ"، "ވައިރަސް" އަދި "ބަލި" ހިމެނޭ ގޮތަށް 2019 ވަނަ އަހަރާ ގުޅުވައިގެންނެވެ. އެ ގޮތުން "ކޮ" ރަމްޒުކޮށްދެނީ "ކޮރޯނާ" އެވެ. "ވި" ރަމްޒުކޮށްދެނީ "ވައިރަސް" އެވެ. އަދި "ޑީ" އަކީ "ޑިޒީޒް" ނުވަތަ ބައްޔެވެ. "19" އަކީ ބަލި ފެތުރެން ފެށި އަހަރެވެ. ވައިރަސް ފެތުރެން ފެށިކަން ފުރަތަމަ އިއުލާން ކުރީ ޑިސެމްބަރު 31، 2019 ގަ އެވެ. އާ ކޮރޯނާވައިރަހަށް ކުރިން ކިޔަމުން އައީ ނޮވެލް ކޮރޯނާވައިރަސް ނުވަތަ "2019-އެންކޮވް" އެވެ. "އެން" އަކީ ނޮވެލް އަދި "ކޮވް" އަކީ ކޮރޯނާވައިރަސް އެވެ.
ކޮވިޑް-19 އާ އެކު ދެން އެންމެ ބޮޑަށް އާންމުވި ލަފުޒަކީ ޓެސްޓްކުރުމެވެ. މިއީ ކުރިން ވެސް އާންމު ބަހެއް ނަމަވެސް ބައްޔަށް ޓެސްޓްކުރަން ގޮވައިލަމުން ދިއުމާ އެކު "ޓެސްޓް" މާ ބޮޑަށް ވައިގައި ހިފައި އެއާ އެކު ދެން އައީ ޕޮޒިޓިވް/ނެގަޓިވް ނުވަތަ ދިވެހިން ކިޔާ ގޮތުން ނަމަ ފައްސި/ނައްސިގެ ވާހަކަ އެވެ. ކޮވިޑް-19އާ އެކު ގިނަ ބައެއްގެ އެންމެ ބޮޑު ސަމާލުކަމެއް ހުއްޓިފައި އޮތީ ޕޮޒިޓިވް/ނެގަޓިވް އަށެވެ. މިއިން ރަމްޒުކޮށްދެނީ ބަލިޖެހުމާއި ނުޖެހުމެވެ.
ކަރަންޓީނކުރުމާއި އައިސޮލޭޓްކުރުމަށް ވެސް މިހާރު އެންމެން ފަރިތަވެއްޖެ އެވެ. ބަލިޖެހޭ މީހުން އައިސޮލޭޓްކުރުން ނުވަތަ އެކަހެރި ކުރަމުން އަންނަ އިރު، ބަލީގެ އަލާމާތްތަކެއް ހުރިތޯ ބަލަން ވަކި މުއްދަތަކަށް ކަރަންޓީނުކުރުމަކީ ހުރިހާ ގައުމެއްގައި ވެސް މިހާރު ކުރަމުން އަންނަ ކަމެކެވެ. ހަމަ މިއާ އެކު "ސެލްފް އައިސޮލޭޝަން" އަކީ ވެސް މިހާރު ފަރިތަ ލަފުޒެކެވެ. މިއީ ރައްކާތެރިވުމުގެ ގޮތުން އަމިއްލަ އަށް އެކަހެރިވުމެވެ.
ދެން ލޮކްޑައުން ނުވަތަ ފުރަބަންދެވެ. މި ވަގުތު މުޅި ދުނިޔެ އޮތީ މި ހާލަތުގަ އެވެ. މިއާ އެކު ގައުމުގެ ރައްޔިތުން ތިބެން ޖެހިފައި ވަނީ "ގޭބަންދު" ގަ އެވެ. ކުރިން އުޅުނު ސޯޝަލް ލައިފް ނުވަތަ އިޖުތިމާއީ ދިރިއުޅުމެއް މިހާރު އެއްވެސް ގައުމަކު ނެތެވެ. މިހާރުގެ އުސޫލަކީ އެމީހަކާ އެ މީހެކެވެ. އެ ނޫން ގޮތަކަށް މި ކޮވިޑް-19 ގެ ޝިކާރައިން ސަލާމަތްވެވޭކަށް ވެސް ނެތެވެ. އެހެންވެ މިހާރު މިކިޔާ ސޯޝަލް ޑިސްޓޭންސިން ނުވަތަ އިޖުތިމާއީ ގައިދުރުކުރުމަކީ އަބަދުވެސް ތަބާވާންޖެހޭނެ ކަމެކެވެ. އަދި ވީހާ ވެސް ގިނަގިނައިން އަތް ދޮންނަންވީ އެވެ. އަމިއްލަ ހަށިގަނޑުގެ ސާފުތާހިރު ކަމަށް ވެސް ކުރިއަށް ވުރެ ބޮޑަށް ސަލާމުކަންދޭންވީ އެވެ.
މި ދަތި އުނދަގޫ ބަލިމަޑުކަމުގެ ތެރޭގައި ދެން އެންމެ ބޮޑަށް ދެކެވެނީ ފޭސް މާސްކާއި ސެނިޓައިޒާ އާއި ވެންޓިލޭޓަރާއި ކަރަންޓީނު ފެސިލިޓީތަކުގެ ވާހަކަ އެވެ. އެއާ އެކު ޑޮކްޓަރުންނާއި ނަރުހުން ވަރުބަލިކަމެއް ނެތި ކުރަމުން އަންނަ ބުރަ މަސައްކަތުގަ ވާހަކަ އެވެ. މިހާރުގެ އާންމު ބަހުރުވައިން ނަމަ "ކުރީ ސަފުގައި މަސައްކަތްކުރާ މީހުން" ނުވަތަ "ސިއްހީ އެހީތެރިން" ގެ ވާހަކަ އެވެ.
ދުނިޔޭގެ ހުރިހާ ހިސާބެއްގައި ވެސް ކޮވިޑް-19 ޖެހޭ މީހުން އިތުރުވަމުންދާ އިރު، އެންމެ ގިނައިން ދެކެވެނީ ބަލިޖެހޭ މިންވަރު ދަށްކުރަން ކުރެވޭ މަސައްކަތްތަކުގެ ވާހަކަ އެވެ. ޕީކަށް ދާ ވާހަކަ އެވެ. "ވޯސްޓް ސިނާރިއޯ" ނުވަތަ ބަލީގެ އެންމެ ނުރައްކާ ހާލަތަށް ތައްޔާރުވާ ވާހަކަ އެވެ.
އެހެން ގޮތަކަށް ކިޔާ ނަމަ "ފްލެޓެނިން ދަ ކާވް" ގެ ވާހަކަ އެވެ. ރާއްޖޭގައި، ގުދު، ތެދުކުރުން/ފަތިކުރުން ވެސް އެބަ ކިޔަ އެވެ. ދުނިޔޭގެ ހުރިހާ ގައުމަކުން އެންމެ ބޮޑަށް ފޯކަސްކުރާ ކަމަކީ ވެސް މި އެވެ. އެތައް ބަޔަކު ކޮންމެ ދުވަހަކު ވެސް އެކި ހިސާބުތަކުން ބައްޔަށް ޕޮޒިޓިވްވެ، ޑޮކްޓަރުން ދައްކަމުން ގެންދާ ގްރާފް ނުވަތަ ޗާޓްގެ ރޮނގު ރާސްލާފައި މައްޗަށް އުފުލެމުންދާ އިރު، ހުރިހާ ގައުމަކުން ވެސް މަސައްކަތް ކުރަނީ އެ ރޮނގު ތިރިއަށް ސައިޒްކުރުމެވެ.
ކޮވިޑް-19 އާ އެކު އެތައް ގޮތަކުން ދިރިއުޅުމަށް ވަނީ ބޮޑު ބަދަލެއް އައިސްފަ އެވެ. އޮފީހަށް ދިއުމެއް މިހާރަކު ނެތެވެ. އޭގެ ބަދަލުގައި މިހާރު އޮތީ ވޯކް ފްރޮމް ހޯމް (ޑަބްލިއުއެފްއެޗް) ނުވަތަ ގޭގައި ތިބެގެން މަސައްކަތްކުރުމެވެ. ކިޔަވާ ކުދިން ތިބީ "ހޯމް ސްކޫލިން" ގަ އެވެ. ވިޔަފާރި ބަރޯސާވެފައި އޮތީ "ޑެލިވަރީ" އަށެވެ.
ސޯޝަލައިޒް ނުވެވޭތީ ނުވަތަ އެކަކު އަނެކާ ސީދާ ބައްދަލުނުވެވޭތީ މުއަމަލާތްތައް މިހާރު ކުރަން ޖެހެނީ އޮންލައިންކޮށެވެ. އެހެންވެ މިއީ ހުރިހާ ތަނެއްގައި ވެސް ކުރިއަށް ވުރެ އެތައް ގުނައަކަށް އިންޓަނެޓްގެ ބާރު ބޮޑު ދުވަސްވަރެކެވެ. މިހާރު ވެސް ހުރިހާ ކަމެއް ގުޅިފައި އޮތީ "ސޯޝަލް މީޑިއާ" އެކި ޕްލެޓްފޯމްތަކާ އެވެ.
މި ހުރިހާ ކަމަކާ ހުރެ އިންސާނުންނަށް ދެން އޮތްހާ ވެސް އޮތީ "ނިއު ނޯމަލް" އަށް ފަރިތަވުމެވެ. ޔަގީންވާ ކަމަކީ ކުރީގެ ހާލާތަކަށް ރުޖޫއަނުވެވޭނެކަމެވެ. އެކަމަކު ހުރިހާ އެންމެންގެ ވެސް އުންމީދަކީ "އާންމު ހާލަތެ" ކެވެ. ކަންބޮޑުވާ ކަމަކީ އާންމު ހާލަތަކަށް އަންނާނެ އިރެއް ލަފާކުރަން ވެސް ދަތިވާތީ އެވެ. އެހެންވެ "ސްޓޭ ހޯމް، ސްޓޭ ސޭފް" އެވެ.